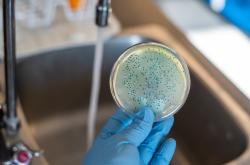

Co se v článku dozvíte?
- Zpochybněna kvalita balených vod Nestlé v nové studii
- Alarmující zjištění o kontaminaci u 30 % balených vod
Zpochybněna kvalita balených vod Nestlé v nové studii
Zpráva zveřejněná na začátku letošního dubna médii jako Le Monde a France Info nás informuje o nedostatečné bezpečnosti některých balených vod společnosti Nestlé. Tato zpráva, která byla předložena Ministerstvu zdravotnictví již v polovině roku 2023, poukazuje na to, že výrobci jako Perrier, Contrex, Vittel a Hépar nedodržují stanovené požadavky na kvalitu.
Alarmující zjištění o kontaminaci u 30 % balených vod
V lednu 2024 média opět zveřejnila zprávu, tentokrát od Generální inspekce sociálních věcí (Igas) z července 2022, která varovala před zakázanými postupy, které výrobci používají k maskování kontaminace stáčených pramenitých a minerálních vod. Tento problém není ojedinělý a zdá se, že postihuje alespoň 30 % značek, včetně Nestlé Waters.
Rozsáhlé kontaminační problémy u zdrojů minerálních vod
Zpráva ANSES odhalila rozsáhlou kontaminaci zdrojů minerálních vod skupiny Nestlé v regionech Grand Est a Okcitánie. Opakovaná mikrobiologická kontaminace včetně fekální kontaminace byla zjištěna u mnoha pramenů. Tato skutečnost je zvláště znepokojivá, protože zdroje těchto vod jsou teoreticky chráněny před riziky znečištění.
Jedním z klíčových zjištění ANSES je, že Nestlé by mělo přehodnotit své využití zdrojů a přestat je používat pro výrobu přírodní minerální vody. Místo toho by se měly tyto zdroje využívat pouze pro stolní vodu nebo vodu pro přípravu nápojů, které mají podstatně nižší spotřebitelskou cenu.
Tato situace nás nutí zamyslet se nad tím, zda je cena, kterou platíme za balenou vodu, skutečně odůvodněná. Je možné, že jsme ochotni zaplatit vyšší cenu za iluzi kvality, která ve skutečnosti nemusí být zaručena. Zpráva ANSES nám připomíná, že je důležité být obezřetní a informovaní spotřebitelé, kteří si zaslouží znát skutečnou hodnotu produktů, které kupují.
Balená voda v akci